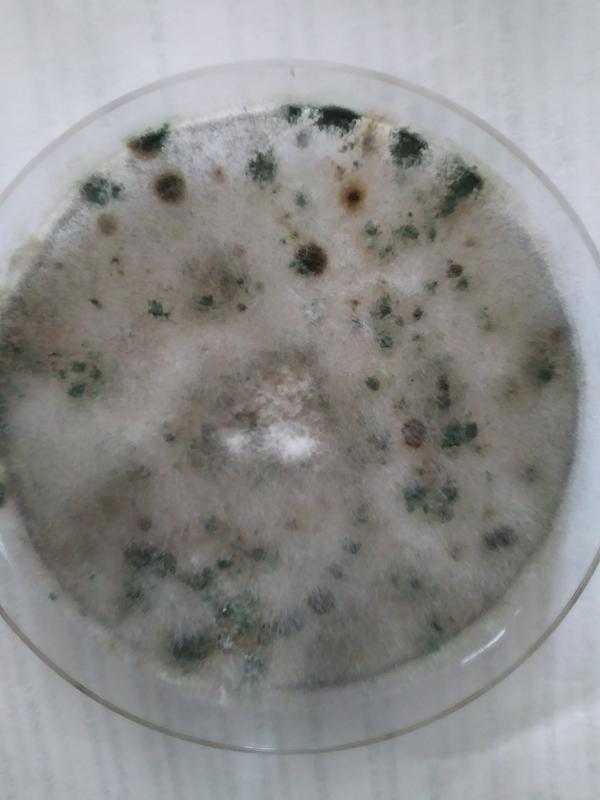

are home depot mold tests accurate
Complete with a petri dish and mold-growth medium this Mold Armor kit is suitable for testing indoor air ventilation systems and surface areas that show visible mold. Are Home Depot Mold Tests Accurate.
:max_bytes(150000):strip_icc()/mold-armor-mold-mildew-removers-fg500-c3_1000-0d2b456d296548f9ac72c376f7ba27de.jpg)
The 7 Best At Home Mold Tests Of 2022 By The Spruce
My mold detective room test kit.

. Get results for 32 different mold types within 5 minutes. There are mold tests homeowners can buy and use themselves. Replace the lid and swirl gently until the bottom is completely covered.
Moisture meters measure the amount of moisture in the air and can help you determine if theres enough humidity for. Its not necessary to hire a professional to test your home for mold. 600 but there is still the 40 lab fee.
Remove the petri dish from the plastic bag and place it on a level surface. The levels of spores that are analyzed by the lab are not accurate and they cannot detect hidden mold so the homeowner cannot properly assess the situation. Are home mold test kits accurate.
Are home mold tests accurate. Here are some of the different types of mold test kits. You may have considered purchasing an at-home mold test kit to check for the presence of mold.
Home Depot Mold Test Accuracy. There are mold tests homeowners can buy and use themselves. Remove the top lid of the petri dish and pour the bottle of mold growth medium into the bottom of the dish.
Its not necessary to hire a professional to test your home for mold. If you have a musty basement or have found water damage somewhere. Are home depot mold tests accurate.
It is an extremely affordable way to test for mold in your home but keep in mind lab results are an additional cost. The kit includes a postage-paid mailer and swabs if you want to have your test result verified by a lab. Another way to test for mold is with a moisture meter.
PROLAB Radon in Water Test KitRW103 The Home Depot. The home results can be a little.

Mold Armor Do It Yourself Mold Test Kit Diy At Home Mold Kit Fg500 The Home Depot

How To Test For Mold In Air Using A Home Test Kit Oh So Spotless

Mold Armor Do It Yourself Mold Test Kit Diy At Home Mold Kit Fg500 The Home Depot
/SPR-Home-v1-The-7-Best-Mold-Removers-of-2021-4583978-primary-69e2398ca7854e2f8b1f9ec66776cc74-3b94bb9a67e54cf088538c9f233cf2c8.jpeg)
The 5 Best Mold Removers Of 2022 By The Spruce

Reviews For Labtech Mold Detection Test Kit Pg 1 The Home Depot

Prolab Mold Test Kit For Home Air And Surface Testing 683431991095 Ebay
Reviews For Pro Lab Mold Test Kit Pg 1 The Home Depot

Pro Lab Lead Surface Test Kit 4 Tests Ls104 The Home Depot

Reviews For Mold Armor Do It Yourself Mold Test Kit Diy At Home Mold Kit Pg 2 The Home Depot

Best Mold Test Kits 2022 Top Ten Reviews

Mold Armor Do It Yourself Mold Test Kit Diy At Home Mold Kit Fg500 The Home Depot

Mymolddetective 1 Room Mold Test Kit Mmd100a The Home Depot

Pro Lab Radon Gas Test Kit Ra100 The Home Depot

The 7 Best Mold Test Kits Mold Help For You

Reviews For Labtech Mold Detection Test Kit Pg 1 The Home Depot

My Mold Detective Mold Test Kit 1 Room Kit Mmd100 The Home Depot

Reviews For Labtech Mold Detection Test Kit Pg 1 The Home Depot

Mold Armor Do It Yourself Mold Test Kit Diy At Home Mold Kit Fg500 The Home Depot
